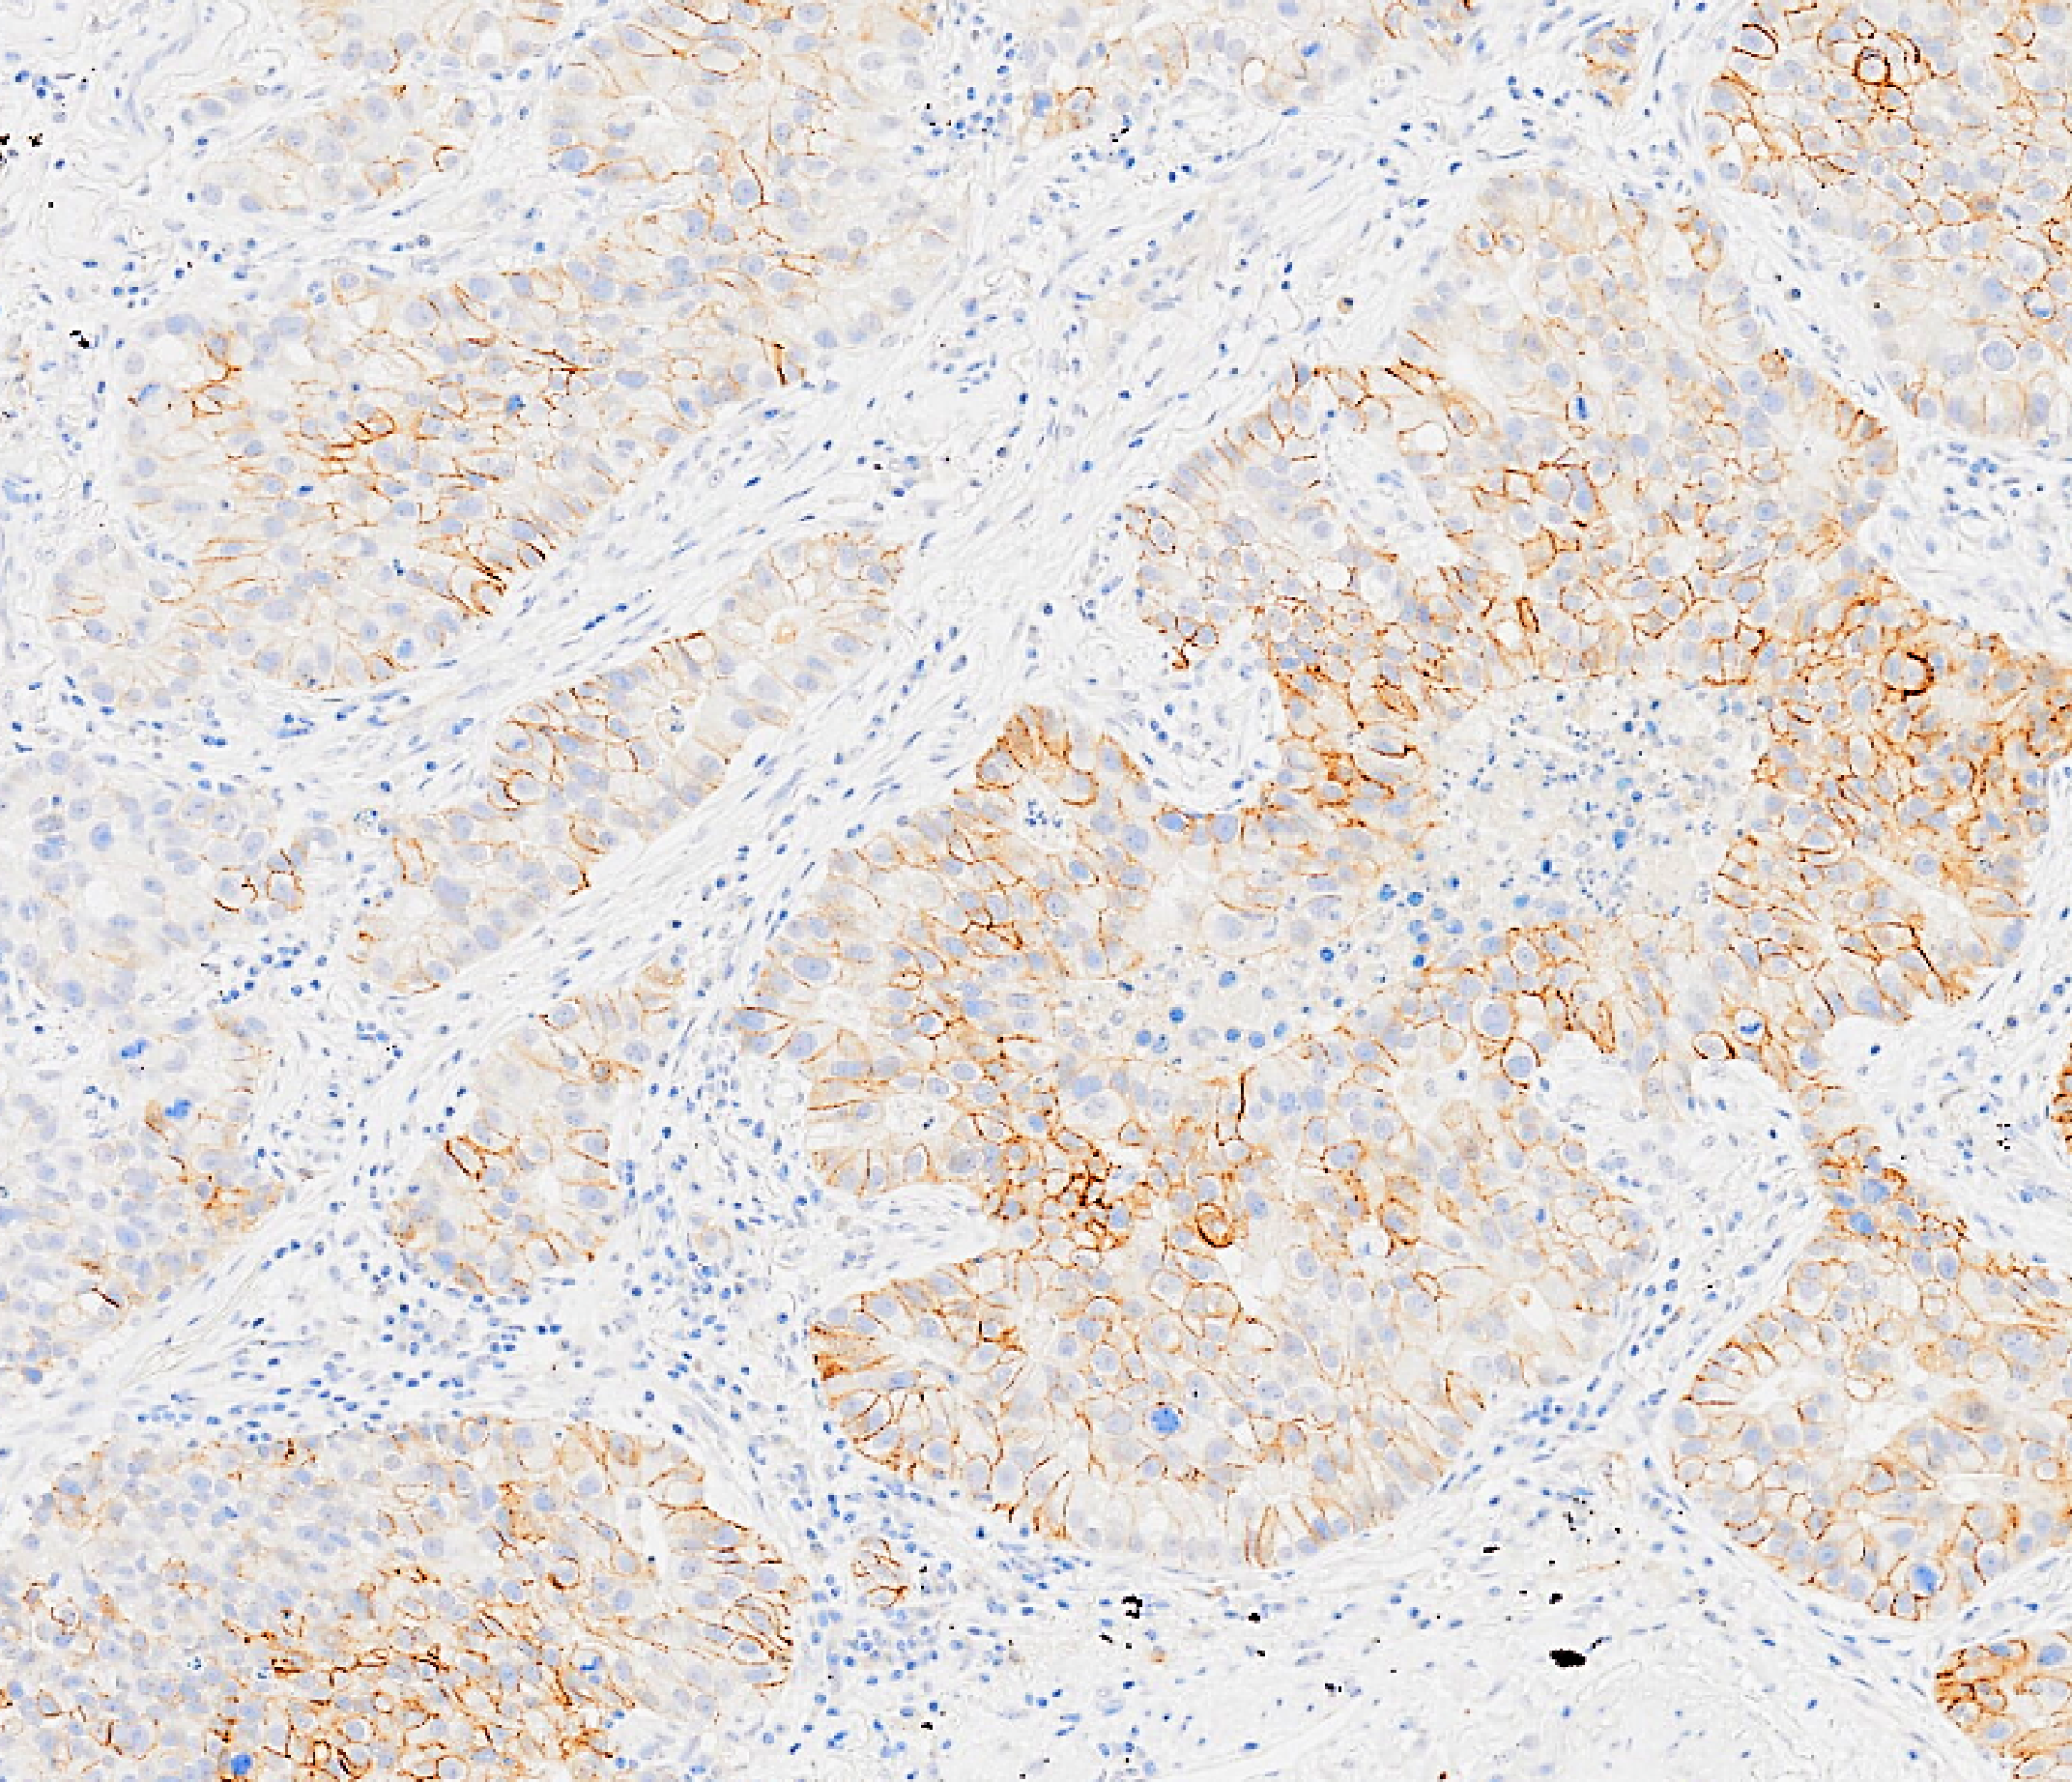

A heterogenous Linux cluster consisting of:
Griffin is five times faster than the Phoenix system it replaces and uses the modern and popular SLURM batch system for effective job management. With its massive computing power, it is a crucial component of SciCom’s High Throughput Data Analysis platform.
Griffin is tightly integrated with our secure central storage system, the High-Performance virtualisation platform, bare metal servers and cloud services.
The platform can cover the entire data analysis lifecycle from
data generation, processing and analysis to publication and archiving. It allows the secure processing and analysis of sensitive high-throughput data.
In addition, we offer application and software development support to enable our scientists to use the latest Bioinformatics methods and technologies for their research.
Special thanks go to OCF – the company who designed and installed the system with ZhiCheng Wang and Anoop Sanalkumar from SciCom.
Griffin, our new supercomputing infrastructure, is a heterogenous Linux cluster consisting of:
100 standard compute nodes
each with 2x Intel CPUs, 24x cores per CPU, 256GB RAM per node
2 high memory nodes
each with 4 x Intel CPUs, 24x cores per CPU and 4096GB RAM per node
An NVIDIA Redstone GPU (graphic processing unit)
system with 4 x A100 GPUs, 2x AMD CPUs, 24 x cores per CPU, 512GB RAM per node
Storage and HPC nodes
are connected via a high-speed InfiniBand
100Gb/s connection
allowing high-speed data transfer between the components
25GbE Access
Accessing the system is much faster than before, as the network bandwidth has been upgraded from 10GbE to 25GbE
The new RStudio
server that can be used to allow web based access to Griffin has been significantly upgraded in response to growing demand
Get in touch
Meet the Facility Team
Dicta omnes ius ut, ei atomorum voluptatum definitionem per. Zril petentium sit at, vel at quis corrumpit. At facilisi per. Sed wisi persius ut, veri novum eu eos, nam ne facer elaboraret.

Director & Senior Group Leader

Deputy Director & Senior Group Leader

Chief Operating Officer

Chief Laboratory Officer
Our Research
Our research spans the whole spectrum of cancer research from cell biology through to translational and clinical studies
Research Groups
Our research groups study many fundamental questions of cancer biology and treatment
Our Facilities
The Institute has outstanding core facilities that offer cutting edge instruments and tailored services from expert staff
Latest News & Updates
Find out all our latest news
Careers that have a lasting impact on cancer research and patient care
We are always on the lookout for talented and motivated people to join us. Whether your background is in biological or chemical sciences, mathematics or finance, computer science or logistics, use the links below to see roles across the Institute in our core facilities, operations teams, research groups, and studentships within our exceptional graduate programme.















